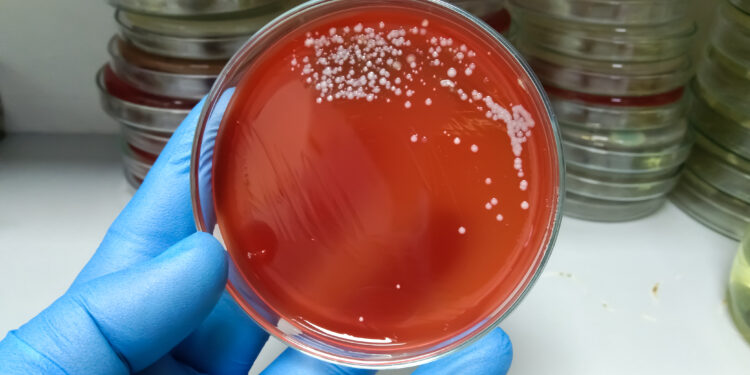
Alerta por brote de estreptococo en Chile: Bacteria Asesina

Profesor del Instituto de Biología de la Pontificia Universidad Católica de Valparaíso entregó detalles de lo peligrosa que puede llegar a ser la Streptococcus Pyogenes, la cual se detectó en el organismo de personas fallecidas debido a la influenza en Ñuble.
El Ministerio de Salud confirmó la presencia de la popularmente “bacteria asesina” en el organismo de personas que fallecieron producto de influenza en la región del Ñuble. Según el subsecretario de Redes Asistenciales, Osvaldo Salgado, se pudo detectar, tras los análisis a las personas que fallecieron producto de la influenza en El Ñuble, que hubo “varios casos” en donde se encontró la Streptococcus Pyogenes.
En ese sentido el profesor del Instituto de Biología de la Pontificia Universidad Católica de Valparaíso, Jorge Olivares, señalo que “la ‘bacteria asesina’ se encuentra normalmente en la microbiota faríngea de todas las personas y se asocia principalmente a enfermedades del tracto respiratorio superior, como la amigdalitis. Sin embargo, en la actualidad existen cepas muy virulentas que pueden ser adquiridas fundamentalmente a nivel intrahospitalario”.
Olivares agregó que “estas cepas ultra virulentas son muy peligrosas y pueden afectar gravemente, sobre todo, a quienes tienen deficiencia en sus sistemas inmunitarios, que podría ser el caso de las personas que padezcan influenza. Si bien, la influenza es una enfermedad viral, produce un gran deterioro en el sistema inmunitario de los pacientes”.
En cuanto a las medidas de prevención, Olivares señaló que “para evitar la diseminación de esta bacteria hay que llevar a cabo programas de vigilancia y seguimiento a aquellas personas con influenza, la cual al ser una enfermedad viral no debe ser tratada con antibióticos. Sin embargo, al detectarse la presencia de la ‘bacteria asesina’ se deben aplicar antibióticos para combatirla”.
Para el profesor del Instituto de Biología de la PUCV, “la detección temprana de la Streptococcus Pyogenes es fundamental. Se le llama ‘bacteria asesina’ debido a que causa la muerte en forma muy rápida, provocando septicemia a nivel generalizado en las personas haciendo que el tratamiento con antibióticos sea muy complejo”.
Complicaciones graves
¿Por qué puede suceder esto? «Las razones pueden incluir principalmente un sistema inmune eficaz, el cual puede controlar la infección sin que se desarrollen síntomas. Y en segundo lugar, cepas menos virulentas. Algunas cepas de estreptococos son menos agresivas y no causan síntomas evidentes dentro de las principales razones», asegura.
«El estreptococos puede ser especialmente peligroso para los niños» por diversas razones, comenta recalcando que «primero, los niños tienen una inmunidad inmadura, especialmente los más pequeños».
Se trata de «sistemas que aún no están desarrollados, y pueden no ser tan eficaces en combatir infecciones», agrega.
Paralelamente, apunta al riesgo de complicaciones. «Las infecciones por estreptococos en niños pueden llevar a complicaciones graves, como la fibra reumática, la glomerulonefritis o la estreptocócica – que es una enfermedad renal-, e infecciones masivas como la fascitis necrotizante».
Tercero, complementa, «en entornos como escuelas, guarderías, las infecciones estreptocócicas pueden propagarse rápidamente debido al contacto cercano, y a la dificultad de mantener una higiene adecuada».
Bebés, adultos mayores y enfermos crónicos
Apuntando a varios tipos de estreptococos, alude a las veces que seguramente la gente ha escuchado hablar «de la bacteria asesina, bacteria come carne. Bueno, es un estreptococos de grupo A».
Y también, asegira, está «el síndrome del shock séptico tóxico. Segundo, tenemos los estreptococos de grupo B. A menudo afectan a los recién nacidos causando infecciones graves. También pueden infectar a las mujeres embarazadas y a personas con enfermedades crónicas y personas mayores».
«Los estreptococos de grupos C y G son menos comunes, pero pueden causar faringitis y, en casos raros, infecciones invasivas», complementa.
Sobre el mecanismo de contagio, insiste en que este está en la superficie contaminada. «Pueden vivir en la superficie durante un tiempo, y el contacto con ellas puede llevar a la infección», asegura aludiendo además a otros riesgos.
«Una persona puede transferir bacterias de una parte de su cuerpo a otra, por ejemplo, de la piel a la garganta a través del tacto», agrega antes de detallar que el tratamiento «es con antibióticos».
Prevención, fundamental
En consecuencia, su llamado es a prevenir, por lo que releva la necesidad de mantener una «buena higiene, lavarse las manos con frecuencia, cubrirse la boca y la nariz al toser o estornudar», a lo que suma «evitar compartir utensilio o vaso», lo que «puede reducir el riesgo de contagio».
Sobre las complicaciones potenciales, destaca «una enfermedad inflamatoria que puede desarrollarse después de una infección estropocócica no tratada o maltratada, afectando el corazón, las articulaciones, la piel y el cerebro. Se dice que la enfermedad reumática es la enfermedad que araña las articulaciones y muerde el corazón, porque actúa a nivel de las vásculas cardíacas».
«Otra complicación importante potencial sería la glomerulonefritis postestropocócica, una inflamación de los riñones que puede ocurrir después de una infección estropocócica de la piel o de la garganta», complementa antes de aludir, en tercer lugar, a «las infecciones invasivas. En este caso las bacterias invaden tejidos profundos, causando condiciones potencialmente mortales».
Por otra parte, García destaca la importancia de la vigilancia y el tratamiento temprano. «Una detección precoz, identificar y tratar rápidamente la infección estropocócica puede prevenir la propagación y reducir el riesgo de complicaciones graves. También es importante fomentar la educación comunitaria, informar a la comunidad sobre los síntomas y las vías de transmisión puede ayudar a reducir la incidencia de estas infecciones», asegura.
Bacteria ampliamente portada por la población
Siguiendo con su análisis, García recalca que «el Streptococcus pyogenes es una bacteria ampliamente portada por la población, generalmente en la piel, que se caracteriza por tener muchos mecanismos de virulencia. Es realmente una máquina asesina, que la hace producir diferentes cuadros, principalmente en niños: el impétigo, las amigdalitis, ya un poco más grave la escarlatina, la fascitis necrotizante (cuando ingresa al tejido y produce necrosis) y el shock tóxico, que es lo que hemos visto últimamente».
Sobre lo que ha pasado ahora, comenta que «esta mayor incidencia y mayor mortalidad, podemos explicarla por dos mecanismos».
«Se podría deber a la aparición de algún clon más virulento, que haya hecho una mutación y produzca mayor cantidad de toxinas, y lo haga más invasivo, o a la deuda inmunológica que dejó la pandemia del covid, sobre todo en los niños», detalla.
«Como tuvimos dos años prácticamente sin virus respiratorios en niños circulando, porque no estaban asistiendo a clases y estaban en sus casas, les quedó esta deuda inmune», complementa.
En consecuencia, explica, «con su sistema de defensa medio en reposo, quizás la influenza produjo una mayor debacle del sistema inmune del niño, y lo hizo ser más susceptible a una invasión de esta bacteria».